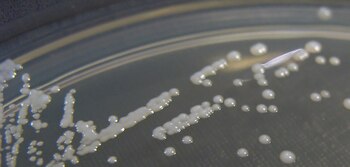
30/12/2012 Cultivo de 'Candida glabrata' en crecimiento
ESPA�A EUROPA MADRID SALUD
ATHAN READING, CON LICENCIA CREATIVE COMMONS

MADRID, 23 (EUROPA PRESS)
Una molécula extraída de una bacteria que vive en el interior de una ascidia actúa como un potente antimicótico, incluso contra patógenos fúngicos multiresistentes a los fármacos como 'Candida auris', según publican el investigador de la Universidad de Wisconsin-Madison Fan Zhang y sus colegas en la revista 'Science'.
Los investigadores descubrieron la molécula, a la que llamaron turbinmicina, después de un cuidadoso examen genómico, metabolómico y antimicrobiano de las bacterias aisladas de una variedad de animales marinos.
Se necesitan urgentemente nuevos tratamientos antimicóticos, ya que casi 2 millones de personas en todo el mundo mueren de infecciones por hongos cada año, y la resistencia a los medicamentos de primera línea va en aumento.
La multirresistencia a los medicamentos 'Candida auris', por ejemplo, ha sido nombrada por los Centros para el Control y la Prevención de Enfermedades de Estados Unidos como una amenaza fúngica emergente mortal que se extiende por los hospitales de todo el mundo.
Zhang y su equipo han demostrado ahora que la turbinmicina tiene una potente actividad antimicótica contra un grupo diverso de patógenos fúngicos humanos en muestras de laboratorio y en ratones infectados, incluidos hongos como 'Candida auris' y 'Aspergillus fumigatus' que son resistentes a las principales clases de medicamentos antimicóticos.
Los investigadores observan que la turbinmicina es bien tolerada por los ratones en dosis terapéuticas. Parece funcionar a través de una vía específica de los hongos, bloqueando el tráfico de vesículas, el proceso central por el cual los materiales son transportados dentro de una célula.
El estudio ofrece un ejemplo de cómo los investigadores que desarrollan nuevos antifúngicos deben buscar enfoques creativos, "incluidos los que aprovechan la diversidad química de la naturaleza sintonizada a lo largo de millones de años de evolución", escribe Leah Cowen en una Perspectiva relacionada.
Últimas Noticias
EE.UU. contempla enviar 10.000 soldados más mientras siguen los ataques: día 28 de guerra
Las bolsas europeas vuelven a la tendencia positiva pendientes de Oriente Medio y el crudo
La FAO alerta del impacto del conflicto en el Golfo sobre la producción agrícola y seguridad alimentaria
El principal responsable económico del organismo internacional advierte que la escalada en el Golfo Pérsico interrumpe el comercio global de insumos clave, amenaza las cosechas, eleva precios e impacta especialmente a países importadores y trabajadores migrantes

Israel bombardea en Teherán espacios para la producción de misiles balísticos
Soltec vuelve a beneficios en 2025, con 12,4 millones de euros, tras la entrada de DVC Partners en su capital
